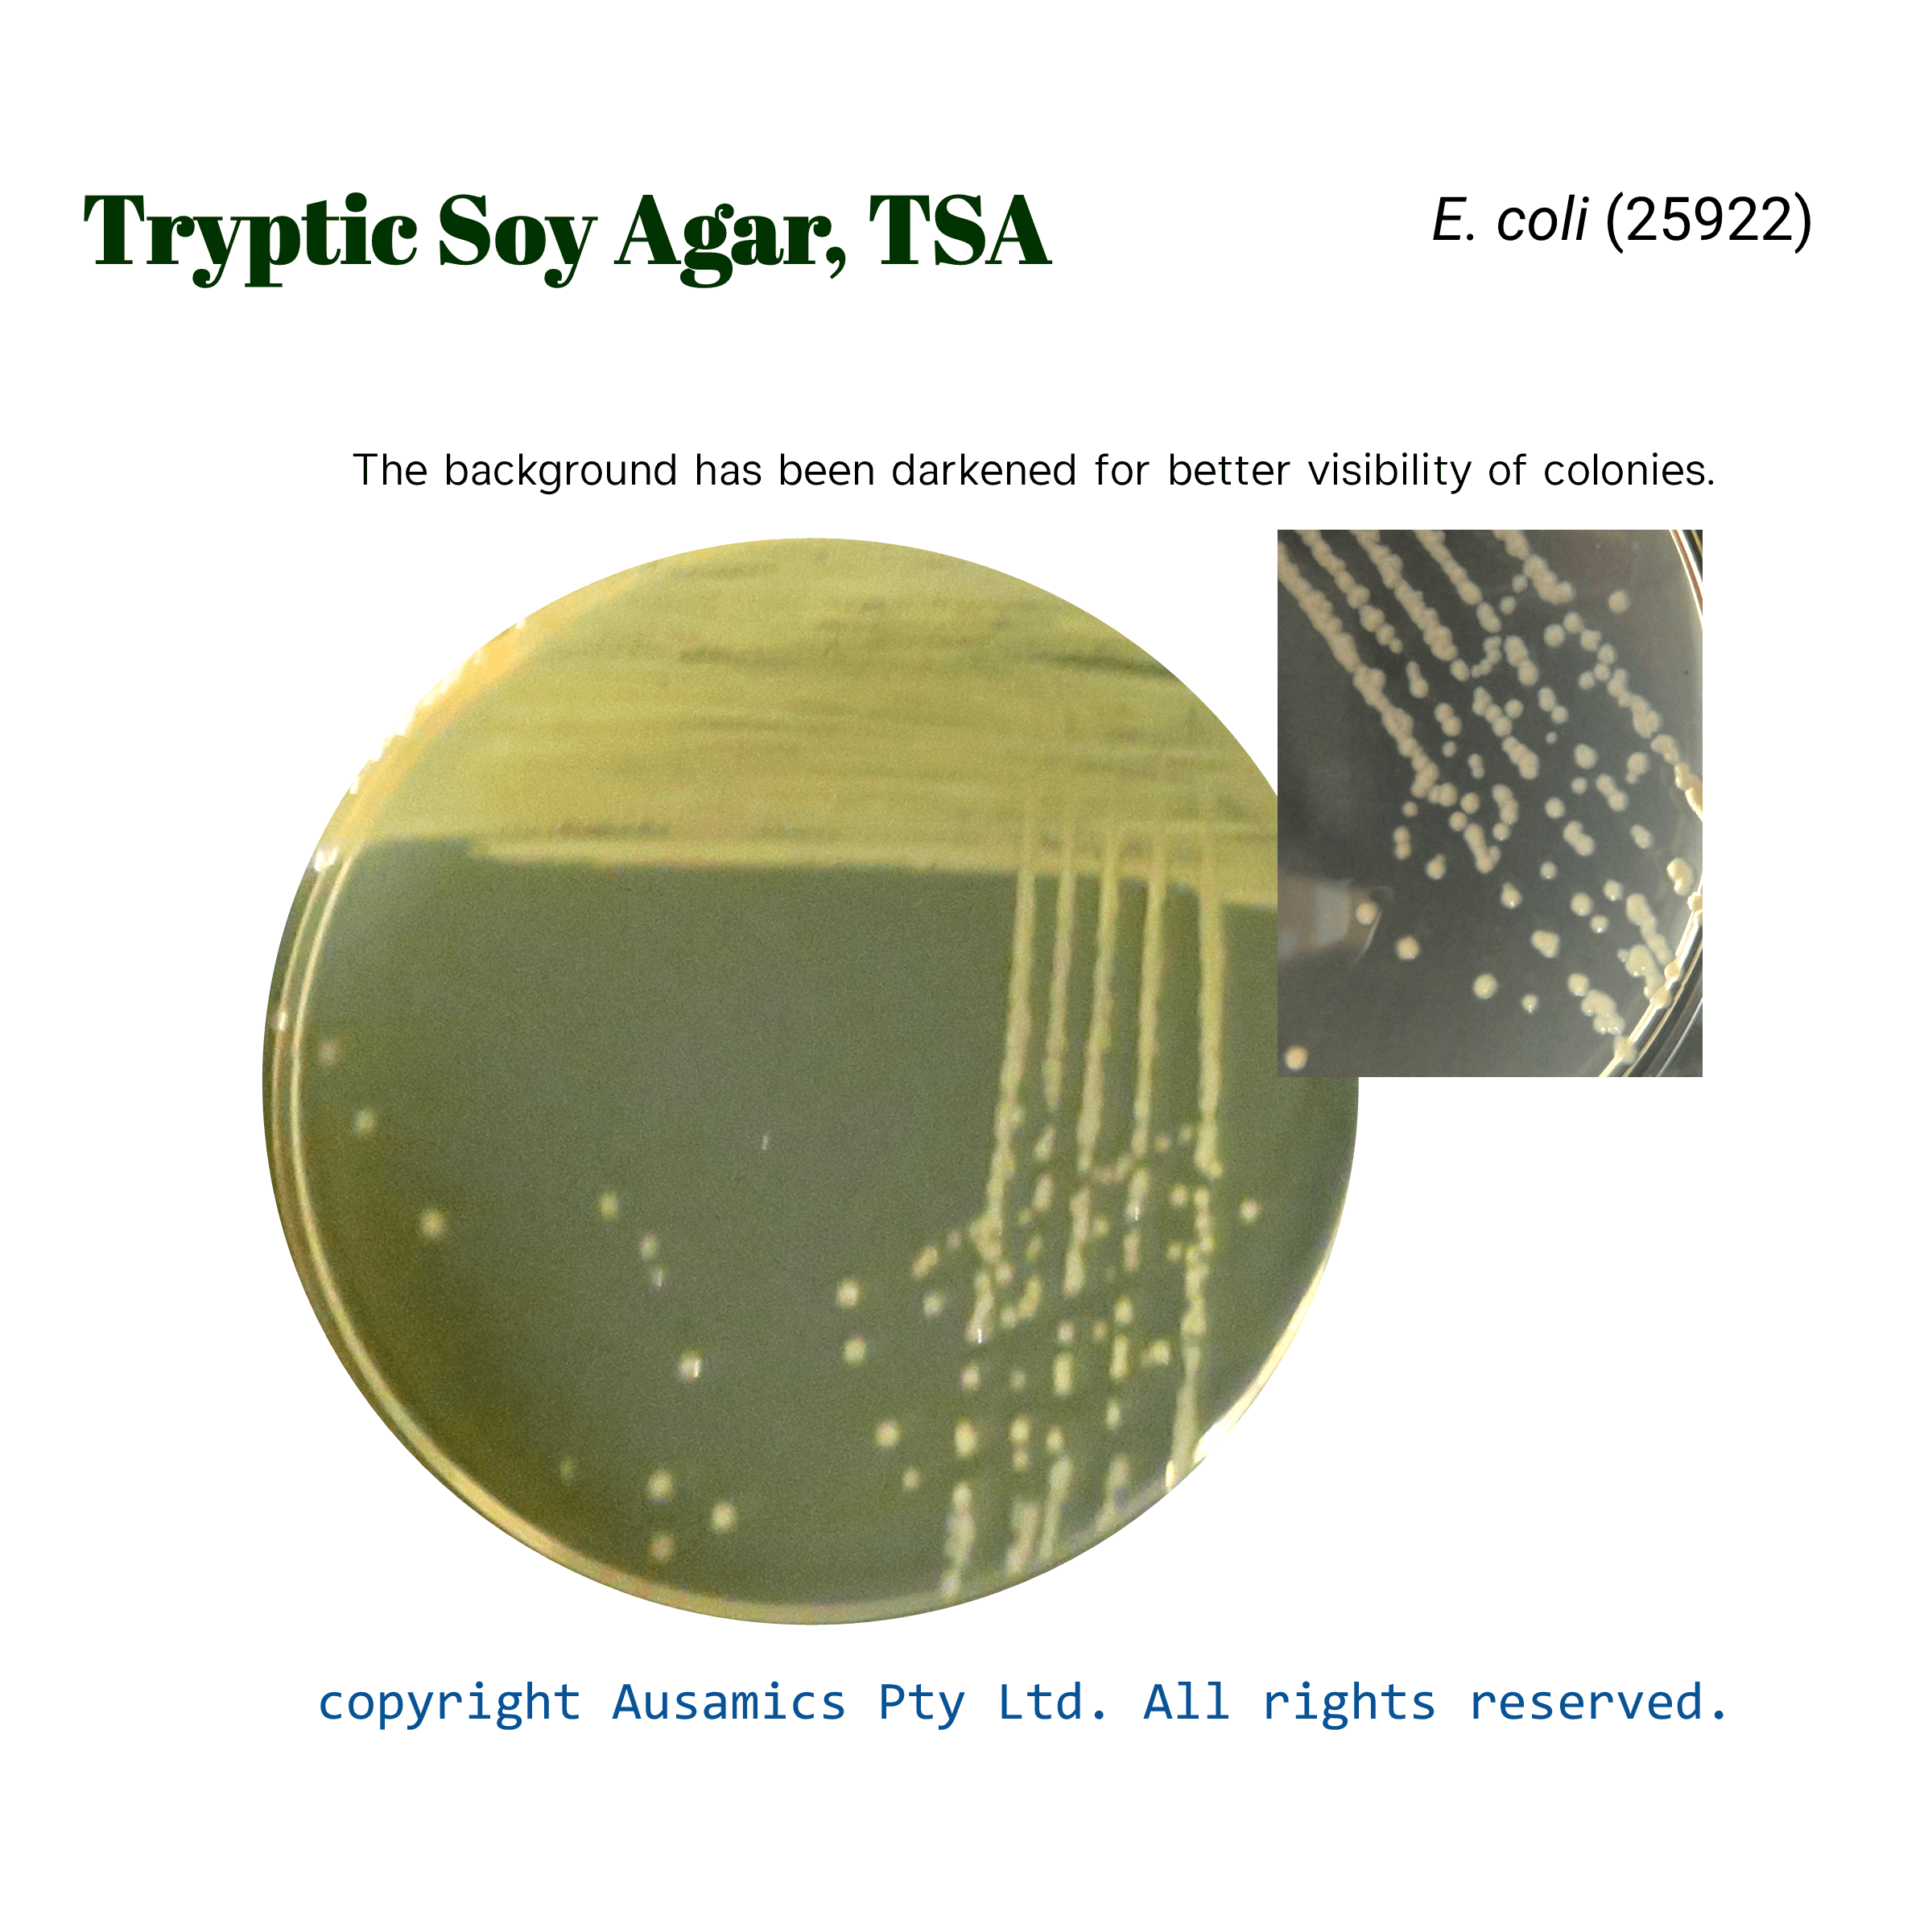
TSA_Ecoli(25922)_Ausamics
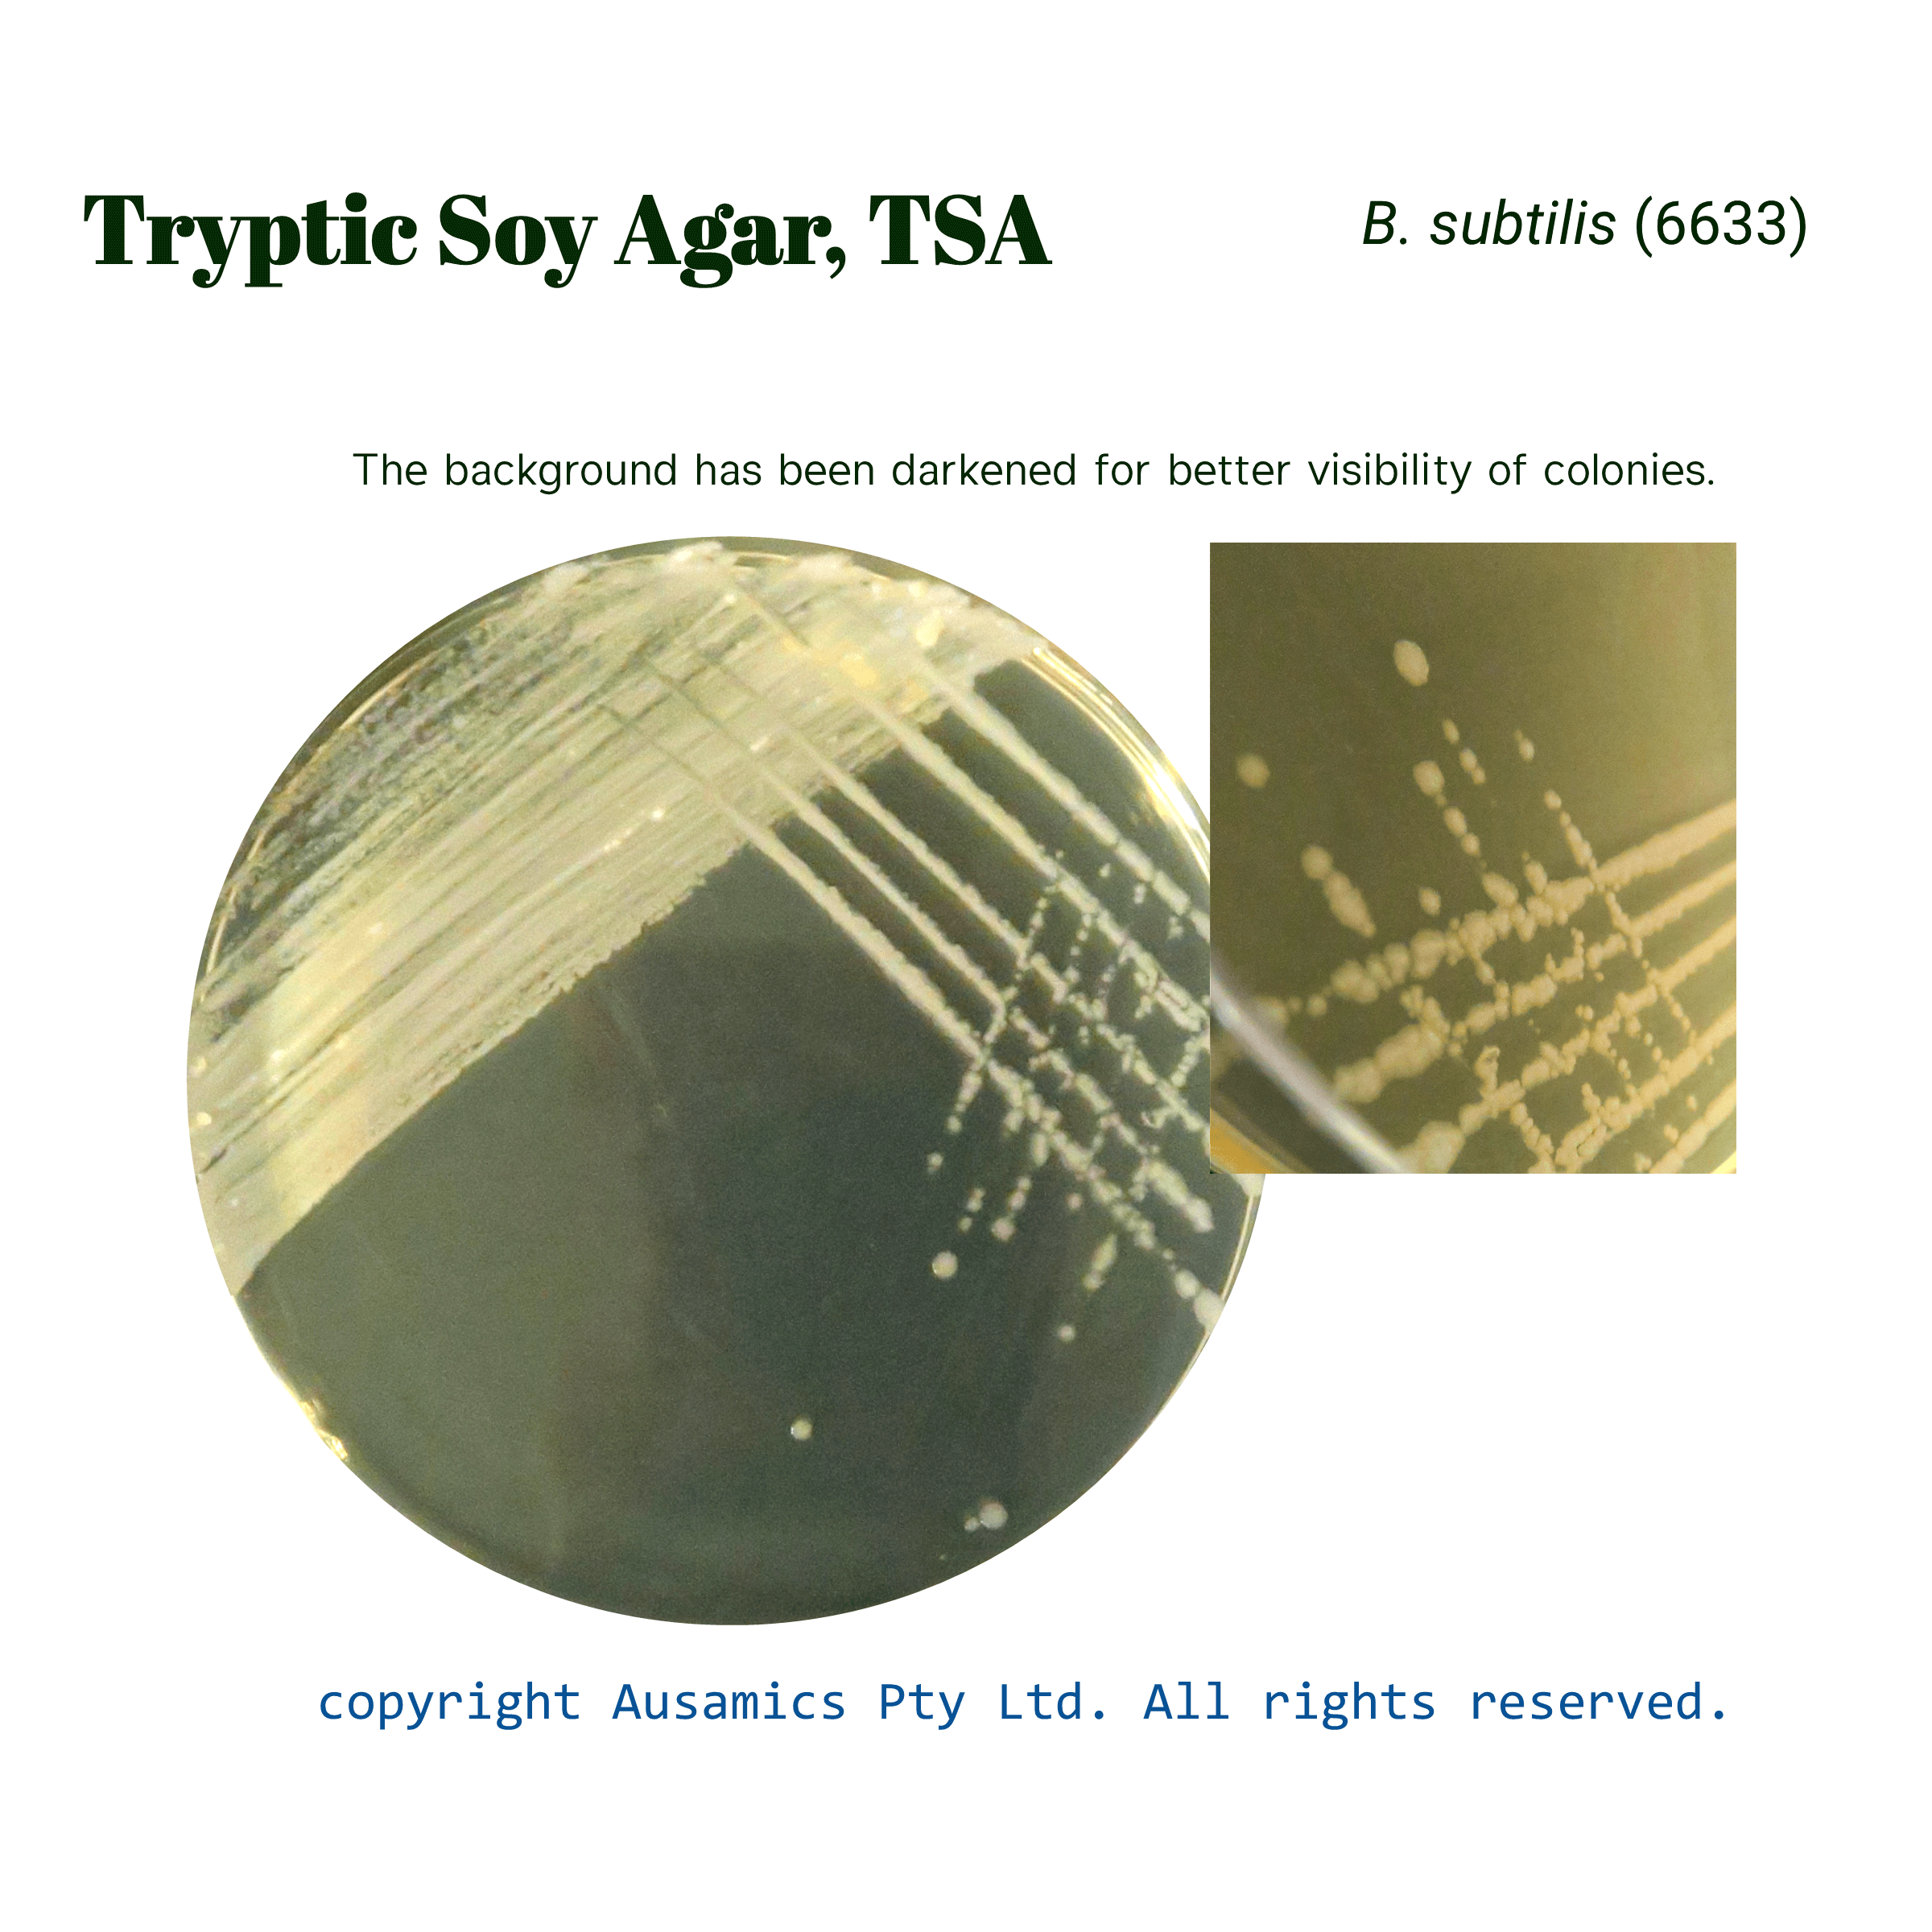
TSA_Bsubtilis(6633)_Ausamics

Tryptic Soy Agar, TSA
Used for the isolation and cultivation of aerobic non-fastidious and fastidious microorganisms.
- Description
- Composition
- Quality Control
- Microbial Test Results
Tryptone Soya Agar (TSA) is a non-selective medium and is commonly used in microbiology to cultivate and enumerate a wide variety of bacteria.
Soy and casein peptones provide a wide range of peptides and amino acids. Sodium chloride preserves osmotic balance. Agar is used as solidifying agent.
Because of adaptability of TSA, it can be used for a wide range of microbiological tasks, such as enumeration and isolation, sterility testing, assessing the effectiveness of preservatives, and serving as a foundation for differential media like blood agar. It is recommended by pharmacopoeias and ISO standards.
Storage
Keep the container at 15-30 °C and prepared medium at 2-8 °C.
| Composition | (gr/L) |
| Pancreatic digest of Casein | 15 |
| Papaic digest of Soybean Meal | 5 |
| Sodium Chloride | 5 |
| Agar | 15 |
| Final pH at 25°C | 7.3 ± 0.2 |
| Dehydrated Appearance | Light beige, free-flowing, homogeneous. |
| Prepared Appearance | Light amber, slightly opalescent. |
| Reaction of 4.0% Solution at 25°C | pH 7.3 ± 0.2 |
| Incubate at 35 ± 2 °C for 18 to 48 hours. | |
| Organism (ATCC) | Recovery |
| Escherichia coli (25922) | Good |
| Candida albicans (10231) | Growth |
| Staphylococcus aureus (25923) | Good |
| Bacillus subtilis (6633) | Growth |
| Streptococcus pyogenes (19615) | Good |